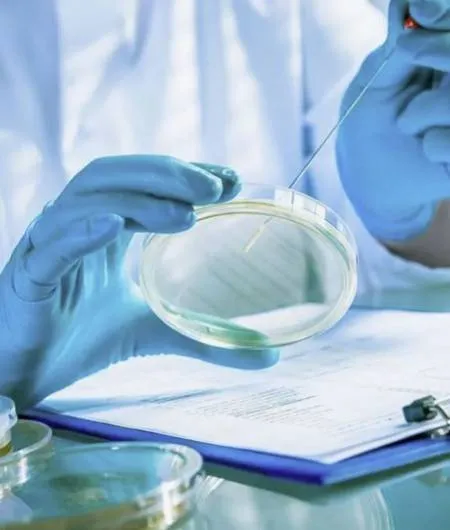

Антибактериальная терапия (или антибиотикотерапия) — ключевой элемент лечения инфекционных заболеваний. Однако её эффективность зависит не только от выбора препарата, но и от своевременной оценки результатов лечения. Грамотный контроль позволяет не только добиться выздоровления, но и предотвратить развитие осложнений, устойчивости к антибиотикам и ненужных побочных эффектов.
Зачем оценивать эффективность антибиотикотерапии?
Любое назначение антибиотика — это осознанное вмешательство в микробиологическое равновесие организма. Поэтому важно понимать, насколько успешно препарат справляется с возбудителем болезни. Цели оценки:
-
Подтвердить, что терапия эффективна и улучшает состояние пациента.
-
Выявить необходимость коррекции лечения при недостаточном ответе.
-
Предотвратить развитие устойчивости микроорганизмов к препарату.
-
Избежать ненужного продолжения терапии при уже достигнутом эффекте.

Когда проводится оценка?
Первичная оценка проводится через 48−72 часа после начала терапии — это оптимальное время, чтобы увидеть динамику. Однако сроки могут варьироваться в зависимости от заболевания, состояния пациента и особенностей препарата.
Как оценивают эффективность?
1. Клиническая оценка:
Главный ориентир — общее состояние пациента. Обращают внимание на:
-
Снижение температуры тела
-
Улучшение самочувствия
-
Уменьшение симптомов (кашля, боли, отека и др.)
-
Нормализацию лабораторных показателей (лейкоциты, СОЭ, CRP)

2. Лабораторные и инструментальные методы:
-
Повторные анализы крови и мочи, посевы биоматериала
-
Рентген, УЗИ, КТ — если требуется визуализация очагов инфекции
-
ПЦР или экспресс-тесты — для оценки наличия патогена

3. Микробиологический контроль:
При тяжелых или хронических инфекциях проводится повторный посев с определением чувствительности к антибиотикам, чтобы убедиться, что возбудитель устранён или заменить препарат при устойчивости.
Признаки неэффективной терапии
- Отсутствие улучшения через 72 часа
- Ухудшение состояния
- Развитие новых симптомов
- Выявление устойчивого возбудителя при повторном анализе
В таких случаях врач принимает решение о смене антибиотика, корректировке дозировки или дополнительной диагностике.
Почему важно не заниматься самолечением?
Неэффективная или неконтролируемая антибиотикотерапия может привести к:
- Хроническому течению заболевания
- Формированию резистентных форм бактерий
- Нарушению микрофлоры и снижению иммунитета
Только врач может грамотно подобрать препарат, дозу, срок лечения и проконтролировать результат.

Заключение
Эффективность антибактериальной терапии — важнейший показатель правильного лечения. Регулярная оценка позволяет вовремя скорректировать курс, сократить длительность болезни и защитить пациента от осложнений. При любых симптомах инфекции — не занимайтесь самолечением, обращайтесь к врачу-терапевту в клинике Медклик — мы подберем лечение, которое подойдет именно вам.